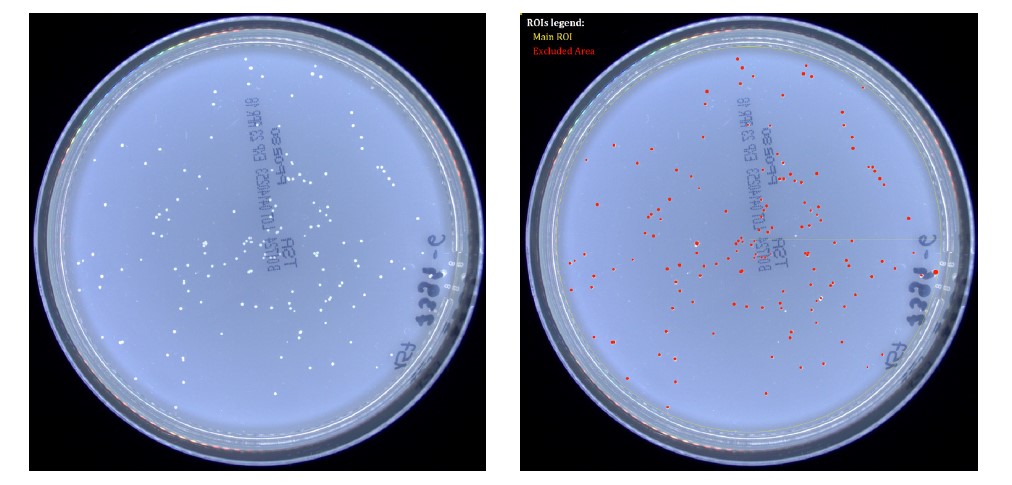

Click 한번으로! 자동콜로니카운터 Quantica500 본문
안녕하세요. 켐코코리아 주식회사입니다.
콜로니 카운팅은 미생물 배양 분석에서 시간이 많이 걸리는 작업 중 하나입니다.
오늘 소개 드릴 장비는 자동콜로니카운터 Quantica500입니다.

90mm 이하 petri dish를 클릭 한번으로 카운팅되며 저장 보관 할 수 있습니다.
다양한 dish type 과 colony type 설정으로 여러분들의 콜로니 카운팅 시간을 줄여보세요.
컴팩트하고 견고한 Quantica500 장비와
깔끔하고 사용하기 쉬운 Software 까지
Quantica 500 & 500+가 궁굼하시다면
켐코코리아로 지금 바로 연락주세요!!
켐코코리아 주식회사
Tel. 043-215-2012
e-mail. ck@chemcokorea.com
'바이오 실험장비' 카테고리의 다른 글
| Quantica 500™ & Quantica 500™+ - 자동 콜로니카운터 (0) | 2022.08.18 |
|---|---|
| 획기적인 자동 콜로니 카운터 QUANTICA 500 & 500+ (0) | 2022.06.29 |
| 자동 세균 계수기 Automatic Colony Counter Quantica 500 & 500+ (0) | 2021.12.23 |
| 자동 세균 계수기 / Automatic Colony Counter (0) | 2021.11.19 |
| 미생물 분석 간편하게~ 미생물 분석키트 MBS /정성분석 정량분석 (0) | 2021.11.19 |
Comments
